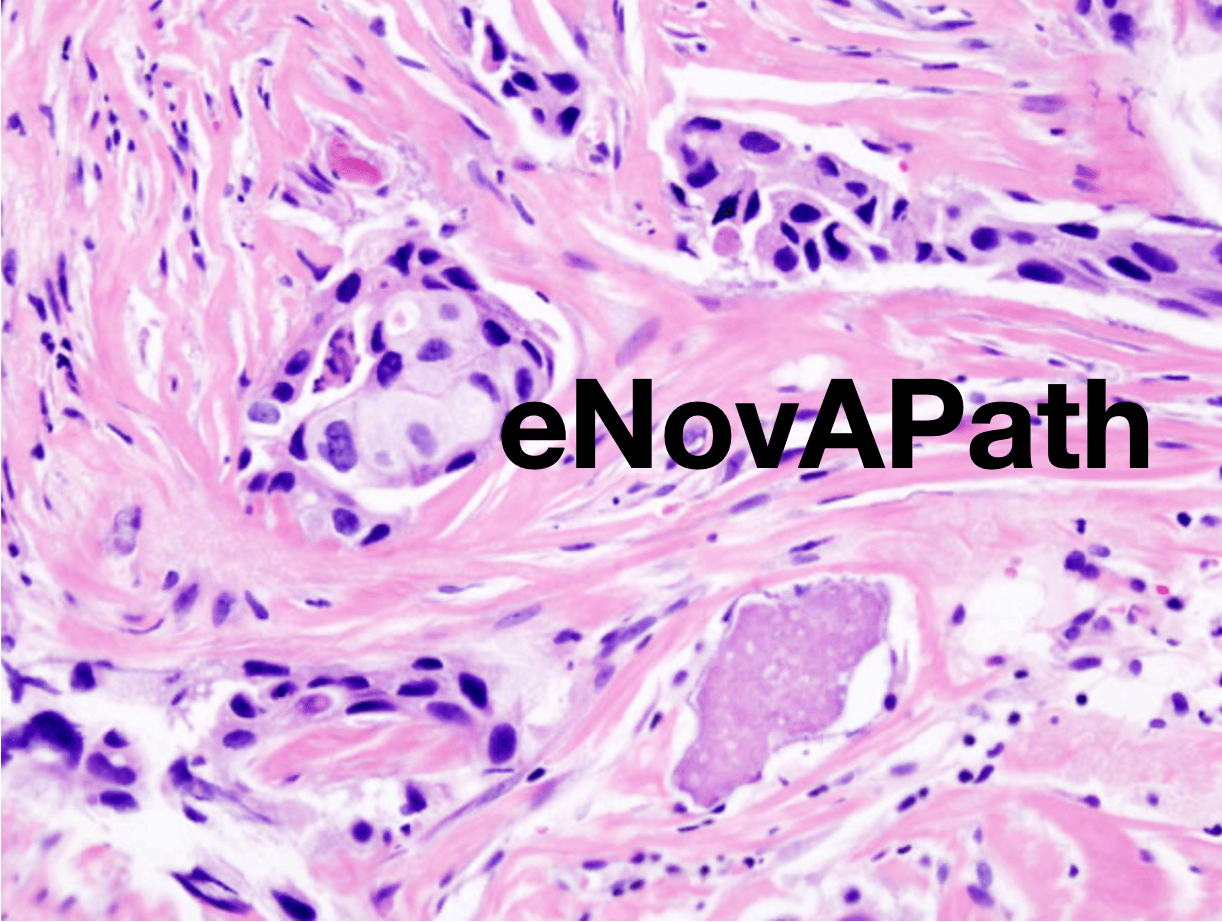

Publicité en cours de chargement...
Contenus à propos de Télémédecine.
Le projet eNovA-Path : une plateforme de numérisation et d’échange des données d’anatomopathologie au service des patients en Nouvelle-Aquitaine
01 juil. 2025 - 00:42,
Actualité
- Propos recueillis par Pauline NicolasLa création d’une plateforme digitale en anatomopathologie entre les trois CHU de Nouvelle-Aquitaine afin d’améliorer la prise en charge des patients et faciliter l’accès aux expertises entre différents établissements de santé reflète l’ambition et les objectifs du projet eNovA-Path qui se déploie a...

MentalTech, vers un Observatoire français de la e-santé mentale
02 juin 2025 - 22:20,
Actualité
- Damien Dubois, DSIHLe 21 mai, le collectif MentalTech a annoncé l’arrivée de dix nouveaux membres et dévoilé sa feuille de route 2025 avec pour ambition de s’affirmer comme l’Observatoire de la e-santé mentale.
![Illustration [SANTEXPO 2025] Rendez-vous sur notre stand K48 pour découvrir nos innovations et des conférences inédites !](/_next/image?url=https%3A%2F%2Fdsih.fr%2Fupld%2Farticles%2F2025%2F05%2F20230523_114151-min.jpg&w=3840&q=75)
[SANTEXPO 2025] Rendez-vous sur notre stand K48 pour découvrir nos innovations et des conférences inédites !
05 mai 2025 - 18:50,
Communiqué
- Axigate LinkÀ l’occasion de SantExpo, du 20 au 22 mai 2025, retrouvez les équipes de la Division Axigate Link du Groupe EQUASENS à SANTEXPO sur le Stand K48 pour échanger autour de vos enjeux métier, découvrir les innovations logicielles, et assister à une série de conférences exclusives animées avec nos client...

Les SI de santé : c’est tout de même assez dingue en 2025 que…
28 avril 2025 - 21:51,
Tribune
-Forcément, dans la cyber on voit passer quasiment tous les projets IT d’une organisation : en principe, ils doivent tous suivre une étape d’homologation, sans parler de ceux qui mettent en œuvre des traitements RGPD enclenchant mécaniquement et a minima une inscription à un registre interne.

Éthicovigilance numérique : premiers signaux d’alerte dans la santé connectée
24 avril 2025 - 15:14,
Actualité
- DSIHLa Délégation au numérique en santé (DNS) publie le premier rapport d’activité de la Plateforme d’éthicovigilance du numérique en santé, un dispositif inédit lancé fin 2023 pour recueillir les signalements d’usagers et de professionnels confrontés à des enjeux éthiques liés aux technologies de santé...

Enovacom : l’interopérabilité au cœur du numérique en santé
20 fév. 2025 - 12:43,
Communiqué
- EnovacomDepuis sa création en 2002, Enovacom a pour enjeu majeur l’interopérabilité des données de santé. Constitué d’une équipe d’experts dédiés à l’interopérabilité, il est aujourd’hui un acteur incontournable de l’e-santé en France qui s’impose comme leader dans ce domaine stratégique.

Patients, personnels de santé : le digital en soutien à la relation humaine au sein de l'hôpital. Enjeux & perspectives
03 fév. 2025 - 10:20,
Actualité
- Par Pauline NicolasA la découverte des tendances présentées lors de cette 7ème édition du D4Evolution qui s’est tenue à Paris le 30 janvier. Faire évoluer le système d’information en ressources humaines en y intégrant de l’IA, recourir au numérique pour favoriser le lien entre la ville et l’hôpital, et optimiser l’exp...

deuxiemeavis.fr et Maiia annoncent la signature d’un partenariat pour proposer aux professionnels de santé un accès facilité à un avis spécialisé sur dossier pour les situations médicales complexes
13 jan. 2025 - 10:01,
Communiqué
- MaiiaParis, France, le 11 décembre 2024 - Maiia, la plateforme de services en ligne de Cegedim Santé et deuxiemeavis.fr, un service qui permet aux médecins et à leurs patients d’obtenir en moins de 7 jours l’avis complémentaire d’un médecin spécialiste, nouent un partenariat inédit au service d'une même ...

Mise en ligne du Vademecum de la télésanté de la FHP-MCO
07 jan. 2025 - 09:21,
Actualité
- DSIH, Damien DuboisFin décembre 2024, la FHP-MCO a annoncé la publication de son outil dématérialisé Vademecum de la télésanté, qui vient compléter le Vademecum des autorisations de santé.

La feuille de route Télésanté des Hauts-de-France
25 nov. 2024 - 21:17,
Actualité
- Damien Dubois, DSIHLe 20 novembre, l’ARS des Hauts-de-France a publié une feuille de route pour les usages de la télésanté dans la région, en déclinaison opérationnelle et locale du projet régional de santé et de la feuille de route nationale du numérique en santé 2023-2027.

Le casse-tête RGPD de la téléexpertise
19 nov. 2024 - 08:30,
Actualité
- Cédric CartauOyez, oyez, braves gens, DSI et RSSI, DPO et chefs de projet ! Vous n’y couperez pas, la téléexpertise est la prochaine « place to be » des DSI qui se respectent.

Le numérique en santé dans le PLFSS 2025
15 oct. 2024 - 09:42,
Actualité
- Damien DuboisLe projet de loi de financement de la sécurité sociale (PLFSS) pour 2025 a été présenté le jeudi 10 octobre au Conseil des ministres dans un contexte d’aggravation du déficit global du pays, qui pourrait atteindre 7 % du PIB en 2025, et du déficit de la branche Maladie, estimé à 14,6 milliards d’eur...
Télé-expertise ville-hôpital : NEHS Digital permet de connecter 600 établissements hospitaliers à la médecine de ville
03 mai 2024 - 16:44,
Actualité
- DSIHLa solution de télésanté Nexus de NEHS Digital s’enrichit d’un portail de télé-expertise ville-hôpital afin de faciliter et de sécuriser les échanges entre experts hospitaliers et médecins de ville. Cette option est d’ores et déjà mise à disposition des établissements franciliens adhérents au projet...

L’essor de la téléradiologie, une opportunité à saisir pour les établissements de santé !
03 mai 2024 - 16:17,
Tribune
- Dr Olivier BabinetLe Dr Olivier Babinet, expert numérique en santé pour l’Agence nationale d’appui à la performance (Anap), nous fait partager sa vision de cette spécialité de la télémédecine.

La parole à… Grégoire de ROTALIER «L’interopérabilité au service d’une vision territoriale des parcours de soins»
08 avril 2024 - 20:04,
Actualité
- Propos recueillis par Delphine GuilgotL’organisation du système de soins est confrontée depuis plusieurs années à la multiplication des parcours complexes. Face à ce nouveau défi, les DSI des établissements doivent continuer à répondre aux besoins spécifiques des prises en charge, tout en garantissant un flux optimal dans les échanges ...

LE CATEL, un incubateur pour « penser en dehors de la boîte »
04 avril 2024 - 17:29,
Actualité
- Propos recueillis par Delphine GuilgotIl a porté une délégation francophone de plus de 40 acteurs de santé au congrès HIMSS 2024 et atterri juste de 8 jours riches d’échanges et de découvertes. Stéphan Haaz, directeur général du CATEL, qui se présente comme un incubateur de Communautés e-santé, revient pour DSIH sur les enseignements de...
Télésanté : plurielle, hybride et collaborative, la pratique gagne du terrain au CHU de Rennes
10 jan. 2024 - 15:56,
Communiqué
- CHU de RennesLa télésanté regroupe les activités de santé médiées par un outil numérique : téléconsultation, téléexpertise, télésurveillance, téléassistance, télérégulation, télésoins... En mettant en relation les patients et les professionnels de santé ou les professionnels de santé entre eux, elle permet la ré...

Face à la déferlante d’attaques, compartimenter le navire avec l’agilité des hyperscalers
18 déc. 2023 - 11:41,
Communiqué
- HPE Aruba NetworkingHPE Aruba Networking simplifie la mise en œuvre de la micro-segmentation pour les réseaux complexes. Si pour la sécurisation du réseau les responsables informatique se sont appuyés sur des pare-feu, des réseaux virtuels locaux (VLAN) et des listes de contrôle d’accès (ACL) pendant des années, il est...
Le dispositif de télémédecine d’Aésio étendu en Éhpad à la cardiologie
17 oct. 2023 - 10:30,
Actualité
- DSIHDébut octobre, le groupe mutualiste Aésio Santé a annoncé que la télémédecine en Éhpad était dorénavant ouverte à la cardiologie pour que les personnes âgées dont l’état de santé le nécessite puissent bénéficier d’une expertise sans avoir à se déplacer.

Les lauréats de l’appel à projets Innovation organisationnelle reposant sur une solution numérique
17 oct. 2023 - 10:27,
Actualité
- DSIHLe 10 octobre 2023, la Direction de l’innovation, de la recherche et de la transformation numérique de l’ARS Île-de-France a communiqué la liste des lauréats de l’édition 2023 de l’appel à projets « Innovation organisationnelle s’appuyant sur une solution technologique ou numérique ».

Enovacom annonce l’acquisition de NEHS DIGITAL et Xperis
26 sept. 2023 - 12:24,
Actualité
- DSIHEnovacom, filiale santé d’Orange Business, a annoncé ce mardi 26 septembre l’acquisition de NEHS DIGITAL et Xperis, deux filiales du groupe Mutuelle Nationale des Hospitaliers. Laurent Frigara, co-fondateur d’Enovacom, revient pour DSIH sur cette annonce majeure pour l’entreprise, dont la taille va ...

Numérique : les médecins français plus sceptiques que leurs homologues européens
21 sept. 2023 - 12:32,
Actualité
- DSIHUn sondage Ipsos présenté à l’occasion de l’événement Pharma HealthTech, organisé par Pharmaceutiques et TechToMed, montre qu’après une adoption « sous contrainte » des outils numériques lors de la pandémie, les médecins français s’en sont un peu détournés.
Télésurveillance médicale : Ramsay Santé adopte Resilience
11 juil. 2023 - 11:42,
Actualité
- DSIHLe 27 juin dernier, Ramsay Santé a annoncé le déploiement de Resilience, une solution de suivi à distance et d’accompagnement des personnes touchées par le cancer, dans 11 de ses établissements.

Médi’Nov Connection 2023 Suivi du patient à distance : une révolution technologique en marche
06 juin 2023 - 11:06,
Actualité
- DSIHLe Congrès Médi’Nov 2023 s’est tenu à Lyon les 31 mai et 1er juin. Lors d'une table ronde animée par DSIH, intitulée « Suivi du patient à distance : une révolution technologique en marche ». Interview blian avec le Dr Frédéric Le Guillou, président de l’association Santé respiratoire France et presi...
NEHS Digital et Xperis au coeur des nouveaux services médicaux et de l’interopérabilité
09 mai 2023 - 11:22,
Actualité
- DSIHNEHS Digital, qui propose aux établissements de santé une solution experte de téléradiologie et de téléinterprétation, va étendre cette offre de services innovants à la médecine nucléaire et à la neurologie. Autre société du groupe MNH-NEHS, Xperis accompagne de son côté les établissements dans le d...

Dedalus conclut un partenariat stratégique avec Conex Santé, visant à encourager, faciliter et étendre la téléexpertise
05 mai 2023 - 21:07,
Actualité
- DEDALUSPromouvoir et faciliter le développement et l’adoption de la télémédecine au sens large est l’ambition affichée des deux entreprises avec ce partenariat technologique. C’est dans un contexte d’innovation permanente pour répondre aux enjeux actuels de la médecine d’améliorer les conditions de travail...

Retour d’expérience sur le déploiement de la téléexpertise dans un hôpital : Interview de Corinne Roldo, directrice de la stratégie au CHRU de Nancy
25 avril 2023 - 11:16,
Communiqué
- OmnidocCorinne Roldo est directrice adjointe au département Stratégie, Innovation et Territoires du CHRU de Nancy. Elle occupe également la fonction de référente Télémédecine de l’hôpital en binôme avec le Pr Mathias Poussel, vice-président de la CME du CHRU et président de la CMG du GHT Sud Lorraine. Elle...

2032 : comment l’innovation va transformer la santé
28 mars 2023 - 10:27,
Actualité
- DSIHLe think tank Innovation Days s’est rendu, le 23 mars, à l’Élysée pour présenter au conseiller technique Industrie, Recherche et Innovation ses propositions d’amélioration d’ici à dix ans de l’offre de soins au bénéfice de tous les patients et des soignants.
E-santé : plus d’un milliard levé par les start-up en 2022
28 mars 2023 - 10:23,
Actualité
- DSIHUne étude de Xerfi sur le marché de l’e-santé en France développe les stratégies des acteurs et les perspectives pour 2025.
![Illustration [Webinar] L’approche logicielle d’HPE Aruba Networking, une solution pour simplifier, rationaliser et automatiser les réseaux](/_next/image?url=https%3A%2F%2Fdsih.fr%2Fupld%2Farticles%2F2023%2F03%2F5047_8883__w1200_dhpe-aruba-networking.png&w=3840&q=75)
[Webinar] L’approche logicielle d’HPE Aruba Networking, une solution pour simplifier, rationaliser et automatiser les réseaux
13 mars 2023 - 12:07,
Communiqué
- HPE Aruba NetworkingLes solutions réseau d’HPE Aruba Networking pour les établissements de santé tirent parti de la technologie SD-WAN. Elle simplifie la gestion des sites distants et optimise les communications entre eux, en utilisant des technologies logicielles pour diriger le trafic de manière dynamique. Avec à la ...

Santé connectée : les établissements de santé perçus comme les seuls acteurs légitimes pour proposer des solutions thérapeutiques digitales
03 fév. 2023 - 12:51,
Actualité
- DSIHLes services de santé publics et privés sont perçus par une majorité de Français comme légitimes pour proposer des solutions ou services digitaux de santé. Les entreprises du médicaments, entreprises technologiques et GAFAM souffrent eux d’une faible légitimité, selon une étude IPSOS.

E-santé : les start-ups françaises ont levé 1,16 milliard d’euros en 2022
27 jan. 2023 - 15:03,
Actualité
- DSIHLe nombre de start-ups françaises ayant mené à bien une levée de fonds a fortement diminué en 2022 par rapport à l’année précédente, mais le ticket médian a fortement augmenté, selon un bilan présenté par le groupe mind Health à l’occasion de la conférence sur « les Grandes Tendances de la E-santé 2...
Développer l'hôpital numérique avec un budget maîtrisé
13 oct. 2022 - 19:35,
Tribune
- Kevin Long, AWSLes systèmes de santé d'Europe et du Royaume-Uni sont sous pression pour maintenir les coûts à un niveau bas. Le passage au cloud pourrait permettre aux hôpitaux d'économiser 5 665 euros par lit d'hôpital et d’ainsi concentrer plus de ressources sur l’innovation tout en maitrisant leurs coûts.

Avec son programme mainUP, Maincare accélère la modernisation de ses solutions
21 sept. 2022 - 15:52,
Communiqué
- MaincareMaincare accélère la modernisation de ses solutions au service des établissements et des professionnels de la santé avec son programme mainUP. Articulé autour de 6 axes, la première phase du programme porte sur trois solutions largement déployées dans les établissements : M-GAM, M-CrossWay et Copilo...
Expérimentations de téléconsultations en médecine générale
24 août 2022 - 11:11,
Actualité
- DSIHL’appel à candidatures « Expérimentations de téléconsultations assistées en médecine générale » de l’ARS Bourgogne – Franche-Comté est ouvert jusqu’au 2 septembre 2022.

Un premier bilan pour l’expérimentation Cnam-Point Vision
26 juil. 2022 - 11:28,
Actualité
- DSIHLe 19 juillet, Point Vision et la Cnam ont présenté le premier bilan de leur expérimentation d’un an du premier centre de télémédecine en ophtalmologie à Saint-Quentin (Aisne).
Changement de gouvernance au Catel
22 juil. 2022 - 14:02,
Actualité
- DSIHLe 4 juillet 2022, le Catel, incubateur de communautés e-santé depuis près de 25 ans, a annoncé le passage de relais de Pierre Traineau, dirigeant et cofondateur de l’agence, à Stephan Haaz, directeur général adjoint depuis sept ans.

Jeunes Médecins pour la levée de la limitation de la téléconsultation
05 juil. 2022 - 11:24,
Actualité
- DSIHLe 30 juin, le syndicat Jeunes Médecins appelait à « lever la limitation du taux de téléconsultation », réduit depuis septembre 2021 à 20 % du volume d’activité pour un médecin libéral.
Les établissements de santé au défi des nouvelles exigences numériques
14 juin 2022 - 20:06,
Tribune
- Christophe Milon, Alcatel-Lucent EnterpriseComment investir efficacement pour assurer la continuité d’activité des établissements de santé ? Dans l’humain, évidemment, et dans le numérique pour accompagner l’émergence de l’hôpital du XXIe siècle.

En direct de SANTEXPO 2022 : Dedalus, le CHU de Montpellier et l’Université de Montpellier lancent ERIOS, un centre de R&D sur les usages des logiciels en santé
19 mai 2022 - 15:07,
Actualité
- DSIHL’éditeur Dedalus, le CHU de Montpellier et l’Université de Montpellier ont annoncé le 18 mai, lors du salon SANTEXPO 2022, le lancement du projet ERIOS, un lieu d’expérimentation inédit sur les usages des logiciels en santé. Basé sur une logique de co-construction, il va dans un premier temps se co...
L’innovation dans le monde de la santé portée par le cloud
17 mai 2022 - 09:32,
Tribune
- Mathieu Jeandron, AWSLa médecine s’est toujours appuyée sur les nouvelles technologies pour améliorer les diagnostics et les traitements. On assiste à présent à une explosion des données de santé qui constituent le moteur de l’innovation d’une médecine qui s’adapte dans le même temps aux contraintes de la société modern...

Lancement de l’Institut national de la e-santé
17 mai 2022 - 09:21,
Actualité
- DSIHL’Institut national de la e-santé, institué au Mans le 5 mai 2022, veut promouvoir la connaissance et le développement de l’écosystème de l’e-santé par la formation et l’accompagnement de ses acteurs. Rencontre avec son président, le Pr Fabrice Denis, oncologue.

Charte de la téléconsultation par l’Assurance maladie
19 avril 2022 - 11:30,
Actualité
- DSIHLe 6 avril 2022, la Cnam a publié une charte de bonnes pratiques de la téléconsultation listant les recommandations et obligations de la pratique de l’activité à distance qui conditionnent sa prise en charge par l’Assurance maladie.

La santé, nouvelle frontière de l’Europe ?
12 avril 2022 - 11:30,
Communiqué
- SANTEXPOLabellisé dans la cadre de la présidence française du Conseil de l’Union européenne, le salon SANTEXPO 2022 rassemblera les acteurs de la santé venus de tout le continent pour réfléchir aux nouveaux chantiers de l’Europe de la Santé à l’heure des risques globaux

Remboursement de l’appli OdySight, expérimentée dans le cadre de l’article 51
15 mars 2022 - 08:37,
Actualité
- DSIHDepuis le 9 mars 2022, OdySight, jeu mobile doté de modules médicaux recommandé dans la surveillance rapprochée de patients atteints de maladies chroniques ophtalmiques, est remboursé après expérimentation dans le cadre du dispositif de l’« article 51 » sur l’innovation.

NEHS DIGITAL recrute 70 CDI pour accompagner le développement de l’entreprise en imagerie médicale et la mise en place du programme du Ségur du numérique en santé
08 mars 2022 - 01:00,
Communiqué
- NEHS DIGITALNEHS DIGITAL, éditeur, intégrateur et distributeur de solutions santé qui accompagne 2 000 cabinets de radiologie et établissements de santé, renforce ses effectifs et annonce une vaste campagne de recrutement pour soutenir son fort développement dans le secteur de l’imagerie. 70 nouveaux collaborat...
Lancement d’un comité stratégique du numérique en santé en Ardèche
21 fév. 2022 - 16:10,
Communiqué
- GCS SaraL’Agence régionale de santé (ARS) Auvergne-Rhône-Alpes, le Groupement de coopération sanitaire (GCS) Sara et l’Assurance Maladie ont organisé un événement digital afin de lancer une instance de concertation en Ardèche permettant de favoriser le développement des projets de e-santé : le Comité d’Anim...

Les propositions du Cnom pour mieux soigner demain
15 fév. 2022 - 08:22,
Actualité
- DSIHÀ la suite de sa consultation « Soigner demain », l’Ordre des médecins a publié Le 10 février 2022 une série de propositions pour transformer notre système de santé, avec un axe consacré au numérique en santé au profit du patient.
E-santé : la HAS publie 4 référentiels de télésurveillance médicale
28 jan. 2022 - 10:38,
Communiqué
- HASLa généralisation du remboursement de la télésurveillance médicale est prévue au plus tard le 1er juillet 2022. La HAS publie aujourd'hui un référentiel pour les solutions de télésurveillance pour chacune des quatre pathologies suivantes : diabète, insuffisance cardiaque chronique, insuffisance réna...

Livre blanc 2022 de la téléophtalmologie
25 jan. 2022 - 09:01,
Actualité
- DSIHEn ce mois de janvier, le think tank Téléophtalmologie lancé par Catel diffuse son livre blanc de la téléophtalmologie.